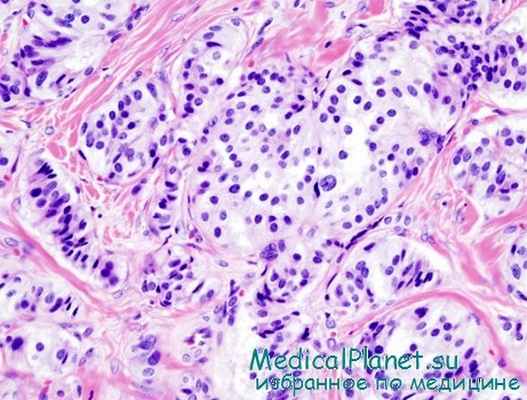
инсулинома

Злокачественные инсуломы. Морфология опухолей островков Лангерханса
Добавил пользователь Алексей Ф. Обновлено: 06.01.2026
Инсулинома — нейроэидокринная опухоль поджелудочной железы, исходящая из b-клеток островков Лангерганса. Инсулинома — редкое заболевание эндокринной системы, в общей популяции диагностируемое с частотой 0,5-1,25 случая на 1 млн населения в год. Из всего многообразия секретирующих панкреатических опухолей инсулинома выявляется с наибольшей частотой, у женщин в 2 раза чаще, чем у мужчин, встречается во всех возрастных группах (Шалимов А.А. и др., Калинин А.П. и др., Grama D. et al.).
Инсулиномы располагаются в толще паренхимы ПЖ, примерно с одинаковой частотой обнаруживаются во всех ее отделах — в головке, теле, хвосте органа. Очень редко (в 1-5% случаев) возможна локализация инсулином за пределами ПЖ (внепанкреатические инсулиномы): в желудке, тощей, подвздошной, двенадцатиперстной, поперечной ободочной кишке, малом сальнике, желчном пузыре, воротах селезенки, а также исключительно редко—в легких, щитовидной железе, надпочечниках (Кузин Н.М., Егоров А.В.). Размеры инсулином в 70-75% случаев не превышают 1-2,2 см в диаметре, но могут варьировать от 0,2 до 10 см и более (Liu Т. Н. и др.).
Морфологические исследования последних лет показали, что для инсулином характерны все типы строения, описанные для нейроэпдокринных опухолей ПЖ (солидный, альвеолярный, трабекулярный, аденомонодобный, карциноидоподобный и др.), причем гистологический полиморфизм и мозаичность строения наблюдаются даже в пределах одной опухоли.
Инсулиномы неоднородны не только морфологически. Они различаются по способности продуцировать, накапливать, хранить и секретировать инсулин и его предшественники. В отличие от нормальной b-клетки, запасающей и хранящей этот гормон в зрелых гранулах, клетки инсулиномы содержат как типичные — кристаллоидные, так и атипичные гранулы, количество, размеры и строение которых варьируют. Атипизм неизбежно сопровождается функциональной неполноценностью или полным отсутствием способности к накоплению и секреции инсулина.
В этой связи различают функционирующие и функционально неактивные опухоли. Функционально неактивные образования, исходящие из островковых клеток имеют более крупные размеры (до 3-5 см и более) и чаще подвержены озлокачествлению.
В последние годы пересмотрен вопрос о преимущественно доброкачественном строении инсулином, что обусловлено диагностикой отдаленных рецидивов заболевания у значительного числа успешно прооперированных больных. По данным некоторых авторов, злокачественные опухоли составляют до 30% и более. Однако общепризнано, что, даже являясь медленно растущими, потенциально злокачественными новообразованиями, почти все инсулиномы при своевременной диагностике и адекватном оперативном лечении курабельны и имеют благоприятный прогноз (Гуревич Л.Е., Grama D. et al., Ericsson В. et al.).
Иммуногистохимические исследования нейроэндокринных опухолей ПЖ показали гормональную неоднородность синтезирующих инсулин новообразований. В частности, обнаружено, что большинство инсулином обладают способностью продуцировать не только инсулин и проинсулин, но и другие гормоны, вырабатываемые ПЖ (глюкагон, гастрин, соматостатин, РР, VIP), а также в нормальных условиях в ПЖ не встречающиеся (АКТГ, кальцитонин, СТГ, МСГ, ТТГ и др.). Установлено, что 50-90% инсулином вырабатывают более одного гормона.
С феноменом мультигормональности некоторые авторы пытаются связать полиморфизм клинических проявлений инсулинпродуцирующих нейроэндокринных опухолей ПЖ. Однако этот вопрос остается недостаточно изученным и требует дополнительных клинических исследований.
Злокачественные инсуломы. Морфология опухолей островков Лангерханса
Злокачественные инсуломы. Морфология опухолей островков Лангерханса
Злокачественные аналоги инсулом обычно достигают значительных размеров и локализуются в хвостовой части, редко — в теле и головке поджелудочной железы. Единственным доказательством злокачественного перерождения инсуломы является наличие метастазов. Однако даже при гистологическом исследовании материала поставить диагноз злокачественного новообразования островков поджелудочной железы трудно.
По внешнему виду злокачественные опухоли, растущие из островковои паренхимы, очень папоминают раковые образования поджелудочной железы неинсулярного происхождения. На разрезе такие опухоли серого или розового цвета, плотной, иногда пластической консистенции, без четких границ с окружающей неизмененной паренхимой поджелудочной железы. Как и доброкачественные инсуломы, карциноматозные процессы этого органа чаще всего развиваются из тела или хвоста, значительно реже — из добавочных поджелудочных желез.
При микроскопическом исследовании злокачественные формы инсулом напоминают аденокарциномы. Несомненным критерием злокачественности инсулом служит наличие выраженного инфильтративного роста эпителиальных элементов. Они сравнительно рано метастазируют по лимфатическим путям в регионарныо лимфатические узлы, печень, легкие и другие внутренние паренхиматозные органы. Основными морфологическими проявлениями малигнизации инсуломы считается клеточная анаплазия и атипия, множественные метастазы, прорастание опухолевыми эпителиальными элементами капсулы и окружающих тканей (К. А. Горнак, Ф. Г. Углов), наличие участков некроза.
Соотношение паренхимы и стромы в злокачественной инсуломе обычно такое же, как при простом раке или скирре поджелудочной железы.

Следует отметить, что в некоторых случаях, несмотря на выраженные признаки гипогликемической болезни, хирург не находит опухолевидного образования в поджелудочной железе. При гистологическом исследовании кусочков ткани, взятых из различных участков железы, обнаруживаются признаки диффузной гиперплазии клеточных элементов инсулярного аппарата (М. Sendrail, D. Douglas, Petit, J. Levi, L. Leger, О. В. Николаев, З. Г. Вейнберг).
При тяжелых формах гиперинсулинизма поражается главным образом центральная нервная система. Патоморфологические изменения в этой системе носят примерно такой же характер, как и при аноксии. В сером и белом вещество головного мозга отмечается застойное полнокровие, иногда стаз в кровеносных сосудах, петехиальные кровоизлияния, диффузные и очаговые геморрагии, признаки набухания, вакуолизации ядер ганглиозных клеток, поражение корковых невронов.
В остальных случаях, как отмечает А. П. Аносова, при гиперинсулиновом синдроме поражаются вегетативные отделы центральной нервной системы, мозжечок, ядра гипоталамической области, а также отдельные участки продолговатого мозга.
Инсулома
Инсуло́ма (от лат. insula — остров и -ωμα от ὄγκωμα — опухоль) — под этим понятием объединены функционирующие опухоли островков поджелудочной железы — новообразования альфа-, бета-, дельта- (D)- и PP- (F)-клеток.
Островковые опухоли — это прежде всего аденомы (доброкачественные новообразования) и реже — аденокарциномы (злокачественные новообразования). Около 60 % всех эндокринных опухолей поджелудочной железы — инсулинсекретирующие. Как правило, новообразованиям островков Лангерганса, особенно злокачественным, свойственна полигормональная секреция, «чистые» опухоли являются редкостью, [1] однако превалирование секреции одного из гормонов определяет ведущий клинический симптомокомплекс. Тем не менее, метастазы в случае злокачественной опухоли могут состоять только из одного типа клеток, даже при первично поликлональной опухоли, и наоборот — встречаются опухоли из одного типа клеток, секретирующие разнообразные пептиды. Предполагается существование двух источников происхождения эндокринных опухолей: островкового (откуда произошло их название — инсуломы) и протокового — из полипотентных стволовых клеток протокового эпителия (незидиобластов), способных пролиферировать и дифференцироваться в клетки, секретирующие различные пептиды (источник эктопической продукции гормонов). Чаще они возникают у взрослых в любой части поджелудочной железы, редко имеют собственную капсулу, обладают так называемым зигзагообразным ростом, сходным с инфильтративным. Опухоли, диаметром 2 см, как правило, доброкачественные, а более 6 см — злокачественные. [2]
Содержание
Классификация


Данная диаграмма демонстрирует структурные различия между панкреатическими островками крысы (вверху) и человека (внизу) pars ventralis pancreas — слева; pars dorsalis — справа. Клетки островков окрашены по-разному: альфа-клетки — красным, бета-клетки — синим, дельта-клетки — фиолетовым, PP-клетки — зелёным, эпсилон-клетки — жёлтым. Бета-клетки грызуна, в отличие от человека сгруппированы в характерное инсулиновое ядро.
В клинике прижилась классификация по названию продуцируемого новообразованием гормона, избыток которого определяет клиническую картину. Позже выяснилось, что гормоны продуцируют не только ортоэндокринные клетки — секретирующие гормоны, свойственные физиологической функции островков, но и параэндокринные — клеточное происхождение которых в настоящее время окончательно не установлено, выделяющие гормоны, не свойственные им [3] : гастрин — гастринома, вазоактивный интестинальный пептид — випома, АКТГ-подобную активность — кортикотропинома. Опухоли из параэндокринных клеток также называют APUD-омами. К параэндокринным относятся также некоторые редкие опухоли, секретирующие другие пептиды и простагландины. [2]
- из альфа-клеток — глюкагонома,
- из бета-клеток — инсулинома,
- из дельта-клеток — соматостатинома,
- из PP-клеток — ППома.
Распространённость
Опухоли из островковых клеток встречаются гораздо реже других панкреатических опухолей. Точных данных о распространёности островково-клеточных опухолей нет. Патологоанатомы находят одну аденому на каждые 1 000…1 500 исследований. В клиниках широкого профиля соотношение пациентов с функционирующим новообразованием островков Лангерганса ко всем госпитализированным составляет 1:50 000. [4] Около 60 % всех эндокринных опухолей поджелудочной железы — инсулинсекретирующие. [2]
Инсулома
Инсуло́ма (от лат. insula — остров и -ωμα от ὄγκωμα — опухоль) — под этим понятием объединены функционирующие опухоли островков поджелудочной железы — новообразования альфа-, бета-, дельта- (D)- и PP- (F)-клеток.
Островковые опухоли — это прежде всего аденомы (доброкачественные новообразования) и реже — аденокарциномы (злокачественные новообразования). Около 60 % всех эндокринных опухолей поджелудочной железы — инсулинсекретирующие. Как правило, новообразованиям островков Лангерганса, особенно злокачественным, свойственна полигормональная секреция, «чистые» опухоли являются редкостью, однако превалирование секреции одного из гормонов определяет ведущий клинический симптомокомплекс. Тем не менее, метастазы в случае злокачественной опухоли могут состоять только из одного типа клеток, даже при первично поликлональной опухоли, и наоборот — встречаются опухоли из одного типа клеток, секретирующие разнообразные пептиды. Предполагается существование двух источников происхождения эндокринных опухолей: островкового (откуда произошло их название — инсуломы) и протокового — из полипотентных стволовых клеток протокового эпителия (незидиобластов), способных пролиферировать и дифференцироваться в клетки, секретирующие различные пептиды (источник эктопической продукции гормонов). Чаще они возникают у взрослых в любой части поджелудочной железы, редко имеют собственную капсулу, обладают так называемым зигзагообразным ростом, сходным с инфильтративным. Опухоли, диаметром 2 см, как правило, доброкачественные, а более 6 см — злокачественные.
Содержание
Классификация

Данная диаграмма демонстрирует структурные различия между панкреатическими островками крысы (вверху) и человека (внизу) pars ventralis pancreas — слева; pars dorsalis — справа. Клетки островков окрашены по-разному: альфа-клетки — красным, бета-клетки — синим, дельта-клетки — фиолетовым, PP-клетки — зелёным, эпсилон-клетки — жёлтым. Бета-клетки грызуна, в отличие от человека, сгруппированы в характерное инсулиновое ядро.
В клинике прижилась классификация по названию продуцируемого новообразованием гормона, избыток которого определяет клиническую картину. Позже выяснилось, что гормоны продуцируют не только ортоэндокринные клетки — секретирующие гормоны, свойственные физиологической функции островков, но и параэндокринные — клеточное происхождение которых в настоящее время окончательно не установлено, выделяющие гормоны, не свойственные им: гастрин — гастринома, вазоактивный интестинальный пептид — випома, АКТГ-подобную активность — кортикотропинома. Опухоли из параэндокринных клеток также называют APUD-омами. К параэндокринным относятся также некоторые редкие опухоли, секретирующие другие пептиды и простагландины.
- из альфа-клеток — глюкагонома,
- из бета-клеток — инсулинома,
- из дельта-клеток — соматостатинома,
- из PP-клеток — ППома.
Распространённость
Опухоли из островковых клеток встречаются гораздо реже других панкреатических опухолей. Точных данных о распространёности островково-клеточных опухолей нет. Патологоанатомы находят одну аденому на каждые 1000…1500 исследований. В клиниках широкого профиля соотношение пациентов с функционирующим новообразованием островков Лангерганса ко всем госпитализированным составляет 1:50 000. Около 60 % всех эндокринных опухолей поджелудочной железы — инсулинсекретирующие.
Злокачественная инсулинома
По данным статистики, злокачественные инсулиномы встречаются крайне редко от общего числа случаев гастроэнтеропанкреатических эндокринных опухолей, так как в большинстве своем инсулинома - это доброкачественная опухоль. Мы приводим клинический случай больной 22 лет с диагнозом: злокачественная инсулинпродуцирующая нейроэндокринная опухоль хвоста поджелудочной железы. Множественные метастазы в печень. Органический гиперинсулинизм. В Эндокринологическом научном центре выполнено комплексное обследование пациентки, представлены результаты лабораторной диагностики и их оценка. На базе клиники факультетской хирургии им. Н. Н. Бурденко ММА им. И. М. Сеченова проведено оперативное лечение, описаны схемы лечения и ведения больной в послеоперационном периоде.
Ключевые слова
Для цитирования:
For citation:
Гипогликемический синдром характеризуется признаками активации симпатической нервной системы или дисфункции ЦНС, которые обусловлены патологически низким уровнем глюкозы в плазме, имеющим множество потенциальных причин. Гипогликемией принято считать снижение концентрации глюкозы в крови ниже 2,2—2,5 ммоль/л, при этом уровень гликемии не всегда коррелируется с выраженностью клинической симптоматики. Существует несколько причин гипогликемии [3]:
А. Эндогенный гиперинсулинизм.
- Инсулинома.
- Гиперплазия инсулярного аппарата поджелудочной железы.
- Эктопическая продукция инсулина или инсулиноподобных факторов.
Б. Токсическая гипогликемия (инсулин, препараты сульфонилмочевины, алкоголь, пентамин, хинин, салицилаты и др.).
В. Тяжелая органная недостаточность (печеночная, сердечная, почечная, сепсис).
Г. Гормональная недостаточность (надпочечниковая недостаточность, недостаточность гормона роста).
Д. Опухоли не из р-клеток (печени, коры надпочечников, мезенхимомы).
Е. Гипогликемии у детей (неонатальная, глико- генозы, кетогенная).
- Постпрандиальная гипогликемия.
- Постпрандиальный гипогликемический синдром.
Б. При нарушении моторики (пассажа пиши).
- Идиопатический постпрандиальный гипогликемический синдром.
Г. Дефекты ферментов углеводного метаболизма.
- Галактоземия.
- Непереносимость фруктозы.
Д. Аутоиммунный инсулиновый синдром.
Одной из причин эндогенного гиперинсулиниз- ма является инсулинома — инсулинпродуцирующая опухоль, происходящая из р-клеток островков Лангерганса, обусловливающая развитие тощако- вого гипогликемического синдрома. В опухолевых клетках нарушена регуляция секреции инсулина: секреция не подавляется при снижении уровня глюкозы крови. В 85—90% случаев опухоль солитарная и доброкачественная, только в 10—15% случаев опухоли множественные, и крайне редко, в 1% случаев, опухоли расположены вне поджелудочной железы (ворота селезенки, печень, стенка двенадцатиперстной кишки). В 20—25% случаев инсулиномы встречаются в рамках синдрома множественных эндокринных неоплазий 1-го типа — МЭН-1 (синдром Вершера).
Таблица 1. Чувствительность методов топической диагностики инсулином поджелудочной железы [2]
Примечание. ЭндоУЗИ — эндоскопическое УЗИ; АСЗК — артериально стимулированный забор крови; ИОУЗИ — интраоперационное УЗИ.
Частота новых случаев опухоли — 12 на 1 млн человек в год, чаще всего опухоль диагностируется в возрасте от 25 до 55 лет[5].
Диагностика инсулиномы базируется на выявлении классической и патогномоничной для нее триады Уипла [4]:
- Возникновение симптомов гипогликемии (вплоть до потери сознания) натощак или после физической нагрузки.
- Снижение содержания сахара крови (менее
- ммоль/л, или 40 мг%) во время приступа.
- Быстрое купирование приступа внутривенным введением глюкозы или пероральным приемом сахаросодержащих продуктов.
Клиническая картина включает в себя [4]:
- неврологические симптомы: головную боль, нарушение зрения, психическую заторможенность, оглушенность, амнезию, судороги, кому;
- адренергические симптомы: слабость, потливость,
тахикардию, сердцебиение, тремор, повышенную возбудимость,
раздражительность, чувство голода, тошноту и рвоту.
’’Золотым стандартом” на первом этапе диагностики гипогликемического синдрома и подтверждения эндогенного гиперинсулинизма является проба с голоданием. Проба проводится в течение 72 ч и считается положительной при развитии триады Уипла [2]. Начало голодания отмечают, как время последнего приема пищи. Уровень глюкозы в крови на пробе оценивают исходно через 3 ч после последнего приема пищи, затем через каждые 6 ч, а при снижении уровня глюкозы крови ниже 3,4 ммоль/л интервал между ее исследованиями сокращают до 30—60 мин. Вторым этапом в диагностике инсулиномы является топическая диагностика опухоли (таблица 1) [3]. Хотелось бы отметить, что для большинства пациентов топическая диагностика с помощью современных методов исследования позволяет на дооперационном этапе установить локализацию опухоли, ее размер, стадию и темпы прогрессирования опухолевого процесса, выявить метастазы.
Трудности в диагностике могут возникнуть при скрытом применении пациентом препаратов инсулина или сульфонилмочевины. Важным доказательством экзогенного введения инсулина является наличие в крови антител к инсулину, низкий уровень С-пептида при высоком уровне общего иммунореактивного инсулина (ИРИ). А с целью исключения гипогликемии, вызванной приемом препаратов сульфонилмочевины, целесообразным будет определение содержания сульфонилмочевины в моче.
Топическая диагностика является комплексной, индивидуальной и должна включать в себя любые из перечисленных методов обследования. Наиболее информативны в диагностике инсулином эндоскопическое ультразвуковое исследование (Эндо, УЗИ) и забор крови из печеночных вен после внутриартериальной стимуляции поджелудочной железы кальцием (АСЗК).
Чрескожно-чреспеченочная катетеризация воротной вены имеет высокий риск осложнений и выполняется по строгим показаниям.
Лечение инсулином в большинстве случаев хирургическое: энуклеация опухоли, дистальная резекция поджелудочной железы, крайне редко применяют гастропанкреатодуоденальную резекцию.
Консервативная терапия проводится в случае нерезектабельной опухоли и ее метастазов, а также при отказе пациента от оперативного лечения и включает в себя:
- химиотерапию: стрептозстоцин, 5-фторура- цил, эпирубицин);
- биотерапию: аналоги соматостатина (октреотид-депо, сандостатин Лар);
- иммунотерапию: интерферон-ос;
- устранение или снижение симптомов гипогликемии: диазоксид, глюкокортикоиды, пропранолол, дилантин [6].
Пятилетняя выживаемость среди радикально прооперированных пациентов — 90%, при обнаружении метастазов — 20%.
Хотелось бы отметить, что в поджелудочной железе могут локализоваться не только инсулинпро- дуцирующие, но и другие нейроэндокринные опухоли (НЭО), которые включают в себя опухоли, продуцирующие гастрин, глюкагон, вазоактивный интестинальный пептид, соматостатин (табл. 2) [1].
Диагностика НЭО не должна ограничиваться только поисками опухоли и ее метастазов. Крайне важным является вопрос: является ли опухоль частью синдрома МЭН-1 или самостоятельным заболеванием? Под синдромом МЭН-1 (синдром Вермера) подразумевается семейно детерминированное заболевание (с частотой наследственной передачи 50%), при котором имеется генетический дефект, расположенный в области длинного плеча хромосомы 11.
Компонентами синдрома МЭН-1 являются: опухоли или гиперплазия паращитовидных желез, НЭО, опухоли гипофиза (пролактинома, сомато- статинома, кортикотропинома и др.) [4]. Алгоритм диагностических методов отображен на рис. 1.
Таблица 2. Нейроэндокринные опухоли поджелудочной железы [1]
Тощаковый гипогликемический синдром
Гиперсекреция соляной кислоты в желудке, язвы, диарея
Водянистая диарея, гипокалиемия
Вазоактивный интестинальный пептид
Некролитическая мигрирующая эритема
Диспепсия, диарея, анемия, желчнокаменная болезнь
Функционально неактивные опухоли
Таким образом, перед врачами, занимающимися проблемами диагностики и лечения НЭО, стоят 4 последовательно решаемые задачи [3]:
- Установление синдромального диагноза.
- Проведение топической диагностики.
- Исключение синдрома МЭН-1.
- Определение тактики лечения.
В рамках обсуждаемой нами темы хотелось бы представить собственное клиническое наблюдение.
Клиническое наблюдение
Больная Л., 22 года, находилась на обследовании в терапевтическом отделении Эндокринологического научного центра (ЭНЦ) с 31.10.07 по 26.11.07 с жалобами на приступы потери сознания, сопровождающиеся судорогами до 1—4 раз в сутки, предвестниками которых являлись головокружение, "туман” перед глазами, потливость.
Анамнез заболевания
С апреля 2007 г. стала отмечать головокружение, слабость. В июне 2007 г. впервые потеря сознания с судорогами. При обследовании по месту жительства выявлена гипогликемия 1,8 ммоль/л, С-пептид 8,0 (норма 0,5—3,2) нг/мл. ИРИ не исследовали, проба с голоданием не проводилась. По данным компьютерной томографии (КТ) органов брюшной полости и забрюшинного пространства определяются множественные очаговые поражения печени размером до 25 мм, четких данных за наличие образования поджелудочной железы не получено. По данным КТ головного мозга — умеренно выраженный гипер- тензионно-гидроцефальный синдром. Выполнена биопсия образования правой доли печени: опухолевые клетки не получены. Для дальнейшего обследования больная направлена в ЭНЦ.
Из перенесенных заболеваний: детские инфекции, сотрясение головного мозга, острый фолликулярный тонзиллит, хронический гипертрофический зернистый рефлюкс-гастрит, пи- лорит, бульбит. Хронический ишемический очаговый колит, баугинит.
Наследственность отягощена по гипертонической болезни, раку легких, сахарному диабету 2-го типа.
Диагноз на момент поступления: гипогликемический синдром неясного генеза. Множественные образования печени. Хронический гипертрофический зернистый рефлюкс-гастрит, пилорит, бульбит вне обострения.
При осмотре — кожные покровы обычного цвета, подкожная клетчатка развита избыточно, распределена равномерно. Рост 158 см. Масса тела 64,4 кг. Индекс массы тела 25,7 кг/м 2 . По другим органам и системам без особенностей.
Данные лабораторных исследований и диагностических тестов
В гемограмме: ускоренное СОЭ (36 мм/ч), нейтрофилия (69,3%). В биохимическом анализе крови: АЛТ 43,6 (норма 4— 41) Ед/л. Коагулограмма: гиперфибриногенемия. В общем анализе мочи отклонение не выявлено.
Уровень глюкозы капиллярной крови по глюкометру: натощак — 3,2 ммоль/л, через 3 ч после приема пищи — 3,4 ммоль/л, через 4 ч после приема пищи — 2,9 ммоль/л, через 3 ч после приема пищи (17 ч 00 мин — 4,6 ммоль/л, через 3 ч после приема пиши (21 ч 00 мин) — уровень глюкозы крови ниже порога чувствительности глюкометра (внутривенно введен раствор 40% глюкозы), на ночь — 3,6 ммоль/л, после 6-часового голодания (3 ч 00 мин) — 2,4 ммоль/л, 6 ч 00 мин — 3,1 ммоль/л, утром натощак уровень глюкозы крови ниже порога чувствительности глюкометра (внутривенно введен раствор 40% глюкозы).
Проба с голоданием:
Исходно через 3 ч после последнего приема пищи: глюкоза 3,0 ммоль/л, С-пептид 3,1 (норма 1,1—4,4) нг/мл, ИРИ 30,6 (2,3—26,4) мЕд/мл.
На 3-м часу проба прекращена в связи с появлением неврологических симптомов гипогликемии: психической заторможенности, судорожных подергиваний мышц лица. Глюкоза венозной крови 3,6 ммоль/л, С-пептид 3,8 (норма 1,1—4,4 нг/мл, ИРИ 62,7 (2,3—26,4) мЕд/мл. Таким образом, учитывая полученные данные, было принято решение о проведении повторной пробы; так как в ходе первой пробы четких данных, свидетельствующих о наличии эндогенного гиперинсулинизма не получено, развившаяся симптоматика не соответствует уровню снижения глюкозы в крови: гликемия 3,6 ммоль/л; у пациентки судороги с помутнением сознания.
Повторная проба с голоданием (рис. 2):
Исходно, после ночного сна: глюкоза 0,7 (норма 3,05—6,38) ммоль/л, неврологической симптоматики не наблюдалось, сознание сохранено; С-пептид 2,6 (1,1—4,4) нг/мл, ИРИ 16,3 (2,3— 26,4) мЕд/мл.
На 22-м часу проба была прекращена, пациентка находилась без сознания: глюкоза в венозной крови — 1,8 (3,05—6,38) ммоль/л, С-пептид 2,4 (1,1—4,4) нг/мл, ИРИ 20,2 (2,3—26,4) мЕд/мл (рис. 3).
В ходе обследования пациентки некоторые данные не позволяли четко подтвердить органический характер гиперинсулинизма, а именно: купирование приступов приемом белковой пищи, отсутствие ночных гипогликемий, возникновение симптомов гипогликемии при уровне глюкозы 3,6 ммоль/л, однако при гликемии 0,7 ммоль/л симптомов гипогликемии не наблюдалось.
По данным УЗИ органов брюшной полости: эхографические признаки множественных гипоэхогенных образований правой доли печени без четких контуров, диаметром 1,1—2,4 см, изменения паренхимы поджелудочной железы (расценены как признаки хронического панкреатита).
На мультидетекторной спиральной КТ брюшной полости и забрюшинного пространства обнаружена гиперплазия вилочковой железы с явлениями фиброза. В хвосте поджелудочной железы, вплотную к воротам селезенки определяется образование размером 9—10 мм. Печень не увеличена, структура неоднородная, с наличием множественных очагов различной формы и величины, наибольший размер 2,66 х 2,75 см.
По результатам УЗИ щитовидной и околощитовидных желез патологических образований не выявлено. При эндоскопическом УЗИ четких данных за наличие образования поджелудочной железы не получено.
Для оперативного лечения пациентка переведена в клинику факультетской хирургии им. Н. Н. Бурденко ММА им. И. М. Сеченова.
Диагноз: злокачественная инсулинпродуцирующая НЭО хвоста поджелудочной железы. Множественные метастазы в печень. Органический гиперинсулинизм.
Оперирована 10.12.07: дистальная резекция поджелудочной железы. Лимфаденэктомия. Биопсия метастазов печени. Спленэктомия. При ревизии: асцита нет, в обеих долях печени определяются множественные метастазы от 0,5 до 3 см в диаметре. В дистальном отделе хвоста поджелудочной железы имеется опухолевое образование плотно-каменистой консистенции, размером 0,9 х 1,2 см прилежащее непосредственно к воротам селезенки. В головке и теле железы пальпаторно опухоль не обнаруживается. Отмечаются увеличенные лимфатические узлы мягкоэластической консистенции по ходу печеночно-двенадцатиперстной связки, общей печеночной артерии (рис. 4, см. на вклейке).
При (интраоперационном УЗИ) (ИОУЗИ) отмечается диффузная неоднородность ткани поджелудочной железы. В дистальном отделе поджелудочной железы определяется солидное образование размером 0,9 х 1,2 см, прилежащее к ткани селезенки. В обеих долях печени — множественные метастазы. Надпочечники не изменены. Парааортальные лимфатические узлы не увеличены.
Гистологическое исследование: злокачественная инсулинома с инвазией в ткань поджелудочной железы, метастазами в лимфатические узлы и печень.
Иммуногистохимическое (ИГХ) исследование выполнено в МОНИКИ: клетки опухоли дают положительную реакцию с маркерами нейроэндокринной дифференцировки — хромогра- нином А, синаптофизином и CD56, а также интенсивную реакцию с инсулином. В лимфатических узлах при ИГХ-исследова- нии с синаптофизином, хромогранином А и инсулином, кроме видимых светооптически, выявляются множественные микрометастазы, преимущественно расположенные под капсулой. Имеется также выраженная положительная реакция клеток опухоли с маркерами экзокринной дифференцировки — цитокера- тином 19 и эпителиальным мембранным антигеном, а также с муцином 1-го типа. Индекс пролиферации опухолевых клеток Ki67 равен 18—21%. С другими исследованными гормонами (глюкагоном, соматостатином, гастрином, панкреатическим полипептидом, АКТГ, серотонином и кальцитонином) реакция отрицательная.
Определение статуса рецепторов к соматостатину 2-го и 5-го типа: рецепторы к соматостатину 2-го типа практически отсутствуют. Рецепторы к соматостатину 5-го типа — умеренно выраженная экспрессия.
Заключение: иммунофенотип опухоли соответствует злокачественной (высокой степени злокачественности) инсулинпродуцирующей экзо-эндокринной карциноме.
Послеоперационный период осложнился абсцессом левого поддиафрагмального пространства, который был дренирован под контролем УЗИ. В послеоперационном периоде 4 раза возникали умеренные приступы гипогликемии со снижением уровня глюкозы крови до 2 ммоль/л (преимущественно до первой инъекции октреотид а-депо). В остальном — без особенностей. Швы сняты, рана зажила первичным натяжением. 19.12.07, 23.01.08 и 21.02.08 пациентке сделаны инъекции октреотида- депо 30 мг, в дальнейшем — 28.04.08 и 21.10.08. Проведено 8 курсов химиотерапии по схеме: араноза 1 г в 1-й и 2-й дни, кселода 2 г/м 2 /сут (1 г/м 2 2 раза в день) в 1—14-й дни, перерыв 1 нед.
Осложнений не было. В лабораторных анализах: паратгормон (ПТГ) 2,8 (норма 1,3—6,8) пмоль/л; С-пептид 923 (298— 1324) пмоль/л; инсулин 19 (6—27) мкМЕ/мл; ИФР — 1118 (87— 238) нг/мл.
Контрольные обследования в динамике
Состояние больной удовлетворительное, приступов гипогликемии не было. По данным КТ отмечается положительная динамика (уменьшение в размерах метастазов печени). Приступов гипогликемии не было. Лечение проводилось только октреотидом-депо.
Состояние больной удовлетворительное, жалобы на общую слабость. По данным КТ — уменьшение размеров метастазов. Контрольное обследование — в марте 2009 г.
Таким образом, в описанном наблюдении мы столкнулись с агрессивной клинической картиной течения инсулиномы поджелудочной железы, размеры которой были значительно меньше размеров ее метастазов, и с трудностями лабораторной диагностики опухоли. Необходимо подчеркнуть значимость проявления клинической настороженности в отношении гастроэнтеропанкреатических эндокринных опухолей. Большая часть опухолей обладает мультигормо- нальной активностью, но развитие эндокринного синдрома чаще всего определяется выработкой какого-либо одного гормона. За исключением инсулином в основном речь идет о злокачественных опухолях (инсулиномы в 80—90% случаев являются доброкачественными). В подобных случаях перед врачом возникают существенные трудности в постановке диагноза. Это редкое наблюдение подтверждает необходимость дальнейшего уточнения алгоритма обследования и лечения пациентов с подобной клинической симптоматикой, а также проведения комплексной терапии при злокачественных НЭО.
Читайте также:
